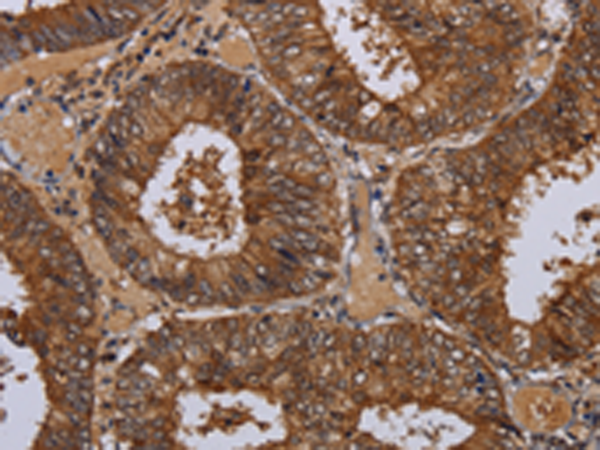
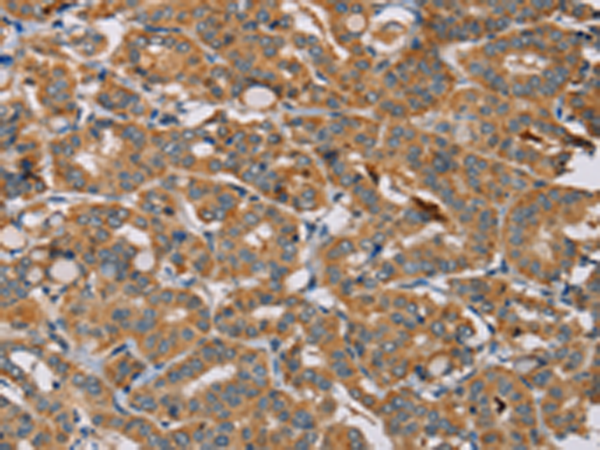

-
分类: 科研抗体货号: P08498别名: MK5; MK-5; PRAK; MAPKAP-K5应用: IHC反应种属: Human, Mouse
-
分类: 科研抗体货号: P08497别名: MORG1应用: IHC反应种属: Human, Mouse, Rat
-
分类: 科研抗体货号: P08515别名: LALP1应用: IHC反应种属: Human, Mouse
-
分类: 科研抗体货号: P08496别名: NAP1; MAP3K7IP3应用: WB,IHC反应种属: Human, Mouse
-
分类: 科研抗体货号: P08502别名: MCPIP; MCPIP1; dJ423B22.1应用: WB,IHC反应种属: Human
-
分类: 科研抗体货号: P08513别名: PAP1B; PAPIB; PAP IB; PAP-1B; UNQ429; LPPM429; REG III; REG-III应用: WB,IHC反应种属: Human, Mouse
-
分类: 科研抗体货号: P08494别名: BUB3L; hBUB3应用: WB反应种属: Human, Mouse
-
分类: 科研抗体货号: P08501别名: CHCR; MBLX; MBXL; MBLX39应用: IHC反应种属: Human, Mouse
-
分类: 科研抗体货号: P08512别名: TRPP8; LTRPC6应用: IHC反应种属: Human, Mouse, Rat
-
分类: 科研抗体货号: P08493别名: CT1.8; MAGE8应用: WB,IHC反应种属: Human

鄂公网安备42018502007531号
鄂公网安备42018502007531号

